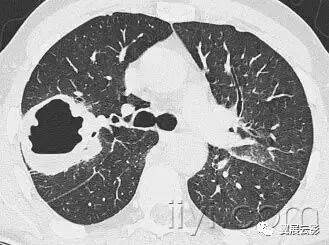
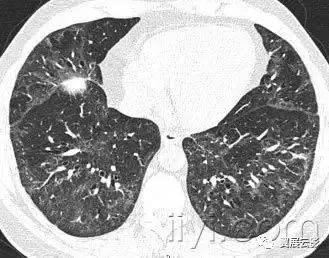

CT入门 | 常见73种胸部影像学术语图解
一、急性间质性肺炎
病理:不明原因的弥漫型肺泡病变。急性期特征为水肿和透明膜形成,晚期表现为含气腔隙和/或间质的机化。病理上难以与急性呼吸窘迫综合征鉴别。
平片和CT:急性期显示为双侧片状磨玻璃影,一些小叶可以不受累,产生地图样影像。在机化期,可以有结构的扭曲,牵拉性支扩,网状密度增高影。

二、空气支气管征
平片和CT图像:空气支气管征是指在肺实变的背景上的含气的低密度气管影。
此征象表明:近段气道通常;由于肺泡内气体吸收导致的不张或肺泡内的气体被病理组织替代(例如肺炎),或者是两者结合。少见的情况有,间质明显增厚,替代了含气腔隙(例如淋巴瘤)

三、空气新月征
平片和CT:空气新月征是空洞壁与内部团块之间的新月形气体积聚。空气新月征是既存空洞内曲菌球形成,或者侵袭血管性曲菌病肺梗死后收缩的特征性表现。但是在其它情况下,也可以出现空气新月征,例如结合,伟格氏肉芽肿,空洞出血或者肺癌。

四、空气滞留(air trapping)
病理:阻塞远端的气体滞留(通常是部分性)
CT:在呼气末CT上表现为实质密度升高程度低于正常肺实质,体积减小程度降低。当空气滞留较轻或者弥漫的时候,比较呼气末和吸气末CT是有帮助的。阻塞性血管病变造成的低灌注也表现低密度,有时候与本病鉴别比较困难。但是可以发现相关的气道病变,与血管性病变不同。

五、主肺动脉窗
解剖:纵膈的一部分,前界是升主动脉,后界是降主动脉,上界是主动脉弓,下界是左肺动脉,内侧为动脉韧带,外侧是胸膜和左肺。
平片和CT:正位胸片上,在主动脉弓以下,左肺动脉以上纵膈的弧形凹入。主动脉迂曲的时候,可以发生形状的改变。多种炎性病变和肿瘤性病变都可以导致主肺动脉窗的淋巴结增大。

六、顶冠或肺尖帽
病理:是肺尖的帽状病变,常由肺内或者胸膜的纤维化,向下牵拉胸膜外脂肪,也可能是慢性缺血导致脏层胸膜的透明斑形成所致。随年龄增长,发病率增加。主动脉撕裂导致的血肿,或者炎症或者肿瘤,导致液体积聚在胸膜腔或者壁层胸膜外,也可以出现此征象。
平片和CT:常见表现是均匀的软组织密度,位于单侧或者双侧肺尖之上呈帽状,下界尖锐且不规则。厚度可变,甚至可达30mm。有时候在横断CT上,肺尖帽可以类似肺尖的实变。

七、肺结构扭曲architectural distortion
病理:结构扭曲的特征是弥漫性或者局限性病变,尤其是间质性纤维化造成的支气管、血管、裂和分隔的异常移位。
CT扫描:肺结构扭曲,常与肺纤维化同时发生,有肺体积的减小。

八、肺不张atelectasis
病理:肺不张是整个肺或者部分肺充气减少。最常见的机制是气道阻塞远端的气体吸收。塌陷和不张是同义词,可以互换使用,尤其是在不张比较严重,伴随肺密度明显升高的情况下。
平片和CT:肺的体积减小,平片上透过度减低,CT密度升高。不张通常同时发生异常的裂、支气管和血管、横膈、心脏和纵隔的移位。肺不张可以有线样肺不张,盘状肺不张,或者层状肺不张。

九、奇静脉食管隐窝
解剖:奇静脉食管隐窝是后纵隔右侧的一个隐窝,右下叶边缘突入其中。上界是奇静脉弓,后界是奇静脉和椎体前面的胸膜,内侧是食管及临近结构。
平片和CT:在正位胸片上,该隐窝表现为垂直的交界面,位于右下叶和临近纵隔之间。上面的交界面凸向左。本交界面消失或者部分变形提示病变(例如隆突下淋巴结增大)。CT显示该隐窝的小病效果佳,因为在正位胸片常无法显示小病变。

十、串珠征
CT:小叶间隔的结节状、不规则的增厚,状如串珠。常见于癌的淋巴扩散,也可见于结节病。

十一、支气管扩张
病理:是不可逆性的局限或弥漫性支气管扩张,通常是慢性感染、近端气道梗阻或者先天性支气管异常造成的。
平片和CT:薄层CT上的形态学标准为:与临近的血管相比,支气管扩张呈印戒征,支气管逐渐变细的形态消失。胸膜下25px内可见气管分支。根据受累气管的形状,支气管扩张可以分为管状、蔓状或囊状。经常伴随关闭的增厚、粘液嵌塞和小气道的异常。

十二、细支气管扩张
病理:是细支气管的扩张,病因是炎性气道病变(具有潜在可逆性),但是纤维化更常见。
CT扫描:当扩张的细支气管充满渗出,壁增厚的时候,可以显示为树芽征和小叶中心性结节。在牵拉性细支气管扩张中,扩张的细支气管是小的、囊样的、管状的气腔,同时可以发现纤维化的征象。

十三、细支气管炎
病理:细支气管炎是各种原因导致的细支气管的炎症。
CT:细支气管炎症的直接征象经常是树芽征,小叶中心性结节,细支气管壁的增厚。

十四、绕支气管
CT扫描:本术语描述病变明显包绕支气管血管术,以其为中心的情况。绕支气管病变包括结节病、Kaposi肉瘤和机化性肺炎。

十五、支气管石
病理:支气管石是临近支气管的淋巴结钙化,突入临近的支气管,最常见于组织浆菌和结核感染。
平片和CT:影像学特征是小的钙化,位于气道之中,或者紧邻。最常发生于右侧中间叶支气管。CT检查效果佳。气管远端的阻塞性改变包括肺不张、黏液嵌塞和支气管扩张。

十六、肺大疱:
病理:直径大于25px(通常为几个cm)的含气腔隙,边界清晰,薄壁(小于1mm)。肺大疱常见临近肺的气肿性改变。
平片和CT:肺大疱表现为圆形的局部透亮影或者低密度,直径25px或者更大,薄壁。常可见多发肺大疱及其他肺气肿的表现(小叶中心型和间隔旁型)

十七、空洞:
平片和CT:空洞是肺实变、肿块或者结节内的充气空隙,呈现透亮区或者低密度区。在肺实变空洞内,肺实变可以消散,只剩下空洞的薄壁。空洞通常是坏死部分通过支气管树排出或者引流后形成。有时候可以有气液平面。空洞不是脓肿的同义词。
十八、小叶中心性:
解剖:小叶中心性用于描述次级肺小叶的支气管血管束中心区域。病理学上也用这一术语描述终末小支气管远端,位于呼吸性细支气管和肺泡管中心的病变。
CT:正常次级肺小叶中心的点状或者线状的密度增高影,胸膜下25px范围内最明显,代表小叶内的动脉,直径约1mm。
小叶中心性异常包括(1)结节(2)树芽征,提示小气道病变(3)由于临近间质的增厚或者浸润导致小叶中心结果更加清晰(4)小叶中心性肺气肿导致的异常低密度。
附图为小叶中心性肺气肿

肺塌陷见肺不张。
十九、肺实变:
病理学:肺实变是指渗出,或者其他疾病成分替代肺泡内气体,导致肺实变。
平片和CT:肺实变表现为肺实质密度的均匀一致性增高,导致肺血管和气道壁边缘不清。有时可见含气支气管征。只有在极少数的情况下,肺实变的密度变化有助于鉴别诊断,例如脂性肺炎是密度减低,胺碘酮中毒时密度增高。
图示为多灶性的肺实变。
二十、铺路石征:
CT扫描:铺路石征表现为磨玻璃影背景上小叶间隔和小叶内线增厚,呈现不规则的铺路石征。铺路石征常与相对正常肺组织分界清楚,边缘规则。该征象最早报道于肺泡蛋白沉积症,也可见于其他类型同时累及肺间质和肺实质的弥漫性肺疾病,包括脂性肺炎。

二十一、囊肿:
病理:囊肿是圆形的,内衬上皮性或纤维性壁的局限性结构。
平片和CT:囊肿表现为圆形的实质低密度或透亮影,与正常肺间分界清楚。囊肿壁厚度不一,但是常为薄壁(小于2mm),其发生通常不伴随肺气肿。囊肿通常含气,但是也可以含有液体或者实性物质。本术语常用来描述淋巴管肌瘤病或朗格汉斯组织细胞增多症时增大的薄壁含气腔隙。厚壁蜂窝样囊肿见于终末期肺纤维化。

二十二、脱屑性间质性肺炎
病理:组织学上讲,脱屑性间质性肺炎的特征是弥漫性远端含气空隙内巨噬细胞的过多聚集。细支气管炎和间质性肺疾病呈明显的细支气管中央性,而脱屑性间质性肺炎巨噬细胞分布均匀,间质受累很轻。大多数的脱屑性间质性肺炎与吸烟史密切相关,但是少部分病例为特发性,或者为遗传性的代谢异常。
平片和CT:磨玻璃影是最主要的异常,呈基地和周边分布。部分病例磨玻璃影内可见小囊样或蜂窝样样表现。

二十三、磨玻璃影
平片和CT:在胸片上,磨玻璃影表现为大片模糊的密度增高影,通常范围比较大,病变内肺血管边界可以不清。在CT图像上表现为模糊的密度增高影,可以观察到器官和血管的边界。病因是含气间隙的部分实变,间质增厚(液体集聚、细胞增生或者纤维化造成)、肺泡的部分塌陷、肺毛细血管床血容量增加或者这几种因素综合作用。最根本原因是部分气体被病理组织替代。磨玻璃影的密度较实变轻,实变时支气管血管束的边缘模糊。

二十四、晕征
CT扫描:晕征是CT上结节或者肿块边缘的磨玻璃影。首先被描述为侵袭性曲菌病边缘的出血征象。实际上晕征是非特异性的,可以见于其它类型结节所致的出血,或者肿瘤的局部肺浸润。(例如腺癌)

二十五、蜂窝征
病理:蜂窝征代表肺组织的破坏和纤维化,包括大量的囊样含气腔隙和厚纤维壁,是各种肺疾病的晚期改变,已经完全失去了腺泡的解剖结构。囊肿的直径大小从数个毫米到数个厘米,囊壁厚度不一,覆盖以化生的细支气管上皮。
平片和CT:在胸片上,蜂窝征表现为相邻很近的环状阴影,直径主要在3-10mm,壁厚主要在1-3mm,形似蜂窝。这一发现提示肺疾患的终末期。在CT上表现为成簇的囊样含气间隙,其直径大约在3-10mm,偶有大于62.5px的。蜂窝征通常见于胸膜下,具有清晰的壁是其特征,是肺纤维化的CT特征。因为蜂窝征常作为肺纤维化的特异性指标,是常见性间质性肺炎的诊断依据。应当慎用本术语,他可能对病人的治疗产生直接影响。

二十六、特发性肺纤维化
病理:特发性肺纤维化特指一类病因不明的慢性纤维化性间质性肺炎,组织学特征与普通间质性肺炎相同。
平片和CT:典型的影像学表现为网状阴影和蜂窝征,主要分布于周边部和基底部。如果存在磨玻璃影,其范围也要小于网状阴影和蜂窝征的范围。本病的特征性影像学表现也可以见于特定病因引起的普通间质性肺炎,例如市面引起的肺纤维化,本诊断常常是排除性诊断。

二十七、梗死
病理:梗死可以导致缺血性坏死,通常是血管病变的结果,例如栓子阻塞肺供血动脉(静脉性梗死少见)。因为支气管动脉的血液供应能够维持组织存活,所以坏死相对少见。肺梗死也可以发生于血管炎性病变(例如伟格氏肉芽肿)。
平片和CT:典型的肺梗死为三角形,或者圆顶状,基底部位于胸膜,尖端致祥肺门。密度增高代表局部出血,其中心组织可以坏死,也可以不坏死。

二十八、小叶间裂增宽
平片和CT:在胸片上,本征象表现为近肺底部的细线状阴影,呈直角达到并与胸膜相接(Kerley B线);最常见于癌的淋巴扩散或者肺水肿。
Keley A线主要位于上叶,长约2-150px,呈放射状指向肺门的细线。最近几年倾向于使用小叶间隔线的解剖名称和增厚,而不是kerley线。在CT上,疾病累及小叶间隔的某一种成分,可能导致小叶间隔增厚,从而使之可见与薄层CT上。小叶间隔的增厚可以是光滑的,或者是结节状的,这对于鉴别诊断有意义。

二十九、小叶间裂
解剖:小叶间裂是常曰10~20mm的条带样结构,形成小叶的边界;在周边部位,大致与胸膜垂直。小叶间裂由结缔组织构成,内容淋巴管和肺小静脉。
平片和CT:小叶间裂可以表现为小叶间的细线状阴影,与小叶内部结构明显不同。一般正常人不可见小叶间裂(正常小叶间裂厚度约为0.1mm),当小叶间裂增厚的时候,可以清晰显示。可以参看小叶间裂增厚的图。

三十、间质性肺气肿
病理:间质性肺气肿的特征是气体位于肺间质之内,尤其是在支气管血管束鞘内,小叶间裂内和脏层胸膜内。最常见于机械通气的新生儿。
平片和CT:成人胸片少见间质性肺气肿,在CT扫描上偶尔可以见到。表现为血管周围透亮影或者低密度晕征和小囊肿。

三十一、小叶内线
CT:当小叶内间质组织异常增厚的时候,小叶内线表现为纤细的线状影。当数量较多时,表现为纤细的网状影,多种病理情况下均可见小叶内线,譬如间质性纤维化和肺泡蛋白沉着症。

三十二、juxtaphrenic peak幕状膈
平片和CT:幕状膈是位于一侧膈顶的小的三角形密度增高影,与一侧肺体积减小有关(例如放疗后纤维化或者肺叶切除术后相关的肺体积减小)正位胸片显示效果佳。下部的叶间裂或者肺内与肺韧带相关的分隔收缩,形成幕状膈向上的幕状突出。
三十三、线样肺不张
平片和CT:线样肺不张是亚段水平的局限性肺不张,呈线样形状,几乎所有的病例都能够延伸到胸膜。线样肺不张通常都是水平的,但是也可以是斜行或者垂直。线样肺不张的厚度可以从数毫米到大于25px。线样肺不张也称为盘样肺不张。
三十四、小叶中心结构
解剖:肺小叶中心结构是次级肺小叶中心的结构,包括小叶中心的动脉和小支气管。
CT:在薄层CT上,尤其是在增厚的情况下(例如肺水肿),在小叶中心的肺动脉及其分支是可以观察到的。这些小血管的直径月0.5到1.0个毫米。但是细支气管壁薄,约0.15mm,正常情况下薄层CT上观察不到。

三十五、小叶
解剖:肺小叶是肺的最小结构,被小的纤维组织隔包绕。小叶也被成为次级肺小叶,包括数目不等的腺泡,呈现不规则的多边形,直径大小从1.0到2.5厘米。小叶中心结构,包括细支气管和伴行的肺小动脉、淋巴管。结缔组织分隔包绕肺小叶,内容静脉和淋巴管,与上叶、中叶的前部、外侧部、邻近纵膈处的周边部发育的较好。
CT:在薄层CT上,肺小叶的三个基本组成成分:小叶间分隔及分隔内结构,小叶中心结构,小叶实质都可以观察到,尤其是在病理状态下。与肺中心部的肺小叶相比,周边部的肺小叶表现趋于一致,形状上更加接近锥形。

三十六、淋巴结病
病理:淋巴结病通常只是用来描述各种原因导致的淋巴结的增大,同义词是淋巴结增大。
CT:正常淋巴结大小范围很大。纵隔淋巴结和肺门淋巴结可以达到12mm。目前大多数情况下纵隔淋巴结上限是短径小于25px,肺门淋巴结短径小于3mm,但是本标准鉴别良恶性淋巴结的可靠性并不是很高。
三十七、淋巴样间质性肺炎
病理:淋巴样间质性肺炎是罕见疾病,特征是弥漫性肺淋巴样增生,主要累及间质。该病属于间质性肺炎的范畴,与肺弥漫性淋巴瘤具有显著的区别。特征包括气管相关的淋巴样组织弥漫性增生,多克隆淋巴细胞弥漫性浸润巧周围,并向间质内扩展。淋巴样间质性肺炎长于自身免疫性疾病或者免疫缺陷病毒感染有关。
CT:主要的异常是磨玻璃影,可见血管旁的薄壁囊肿。也可以发生肺结节、网状阴影,小叶间隔和支气管束的增厚、弥漫性的实变。

三十八、粟粒样
平片和CT:在胸片上,粟粒样代表大量小的、分散的、圆形肺部阴影(直径小于3mm),大小相对均以一致,双肺内弥漫性分布。是结核或者转移性病变弥漫性分布的特征。薄层CT上显示为广泛、随机分布的微结节。

三十九、马赛克征
CT:本征象表现为不同的密度成片状镶嵌,可为间质性病变、闭塞性小气道病变(图)或者血管阻塞性疾病。马赛克征比马赛克样少血或者低灌注具有更强的诊断含义。由于支气管或细支气管阻塞导致的空气滞留可以导致局部的密度减低,在呼气相CT上表现更加明显。
该征象也可以见于间质性肺部疾病,特征是磨玻璃影,此时高密度代表间质性病变,低密度代表正常的肺。

四十、曲菌球
病理:曲菌球是孤立的菌丝相互缠绕形成的肿块,常是曲菌类病原,黏液、纤维素、细胞碎片共同构成空洞成分,常发射跟你在纤维空洞的基础上(例如结核或者结缔组织病)
平片和CT:曲菌球可以随着体位的变化发生变化,部分病例可见空气新月征(图)CT上可以呈现海绵样影像和曲菌球内的钙化灶。同义词是真菌球。

四十一、nodular pattern 粟粒样结节影
本名词尚未明确如何翻译好
平片和CT:粟粒样结节影表现为胸片上无数的小圆形结节,分布弥漫,指教解郁2~10mm内(图)。病变分布广泛但是不一定均匀,在CT上具有三种解剖分布模式:小叶中心性、沿淋巴管或者随机。

四十二、结节
平片和CT:结节在胸片上的表现是:圆形高密度影,边界清楚或者不清,直径月75px。
(a)腺泡结节为圆形或者卵圆形,边界不清,直径5~10mm,一般认为是实变导致腺泡实变造成的。本用法只适用于多发病灶时。
(b) 假结节可以可以类似肺结节,可能是肋骨骨折,皮肤病变,体表的设备,解剖变异或者重叠影。在CT上,结节表现为圆形或者不规则的密度增高影,边界清楚或者不清楚,直径小于75px。
(a) 小叶中心性结节表现为离胸膜表面、裂或小叶间隔数毫米的多发结节。可以是软组织密度或者磨玻璃影,大小从数毫米到数厘米,小叶中心性结节常边界不清。
(b) 小结节直径小于3mm。
(c) 磨玻璃影结节(非实性结节的同义词)表现为肺内模糊的密度增高影,可以辨认支气管和血管的边界。
(d) 实性结节为均匀一致的软组织密度
(e) 部分实性结节包括磨玻璃影部分和软组织密度部分。

四十三、非特异性间质性肺炎
病理:非特异性间质性肺炎的特征是不同程度的慢性炎症或者纤维化均匀累及间质。非特异性间质性肺炎可以说特发性的,也可以见于其它疾病中,例如胶原血管病,高反应性肺炎,药物所致肺疾病,感染或者免疫免疫抑制(包括人类免疫缺陷病毒)
CT:非特异性间质性肺炎薄层CT表现多样,最常见的征象是磨玻璃影,伴随网状影,牵拉性支气管扩张或细支气管扩张,但是蜂窝征很少或者无,病变通常分布于基底段或者胸膜下。
四十四、肺少血
病理:肺少血是肺血容量减少。大多数情况下,为局部性,但也可见全肺范围的肺少血。局部肺少血是由于局部少血区血流减少所致。
平片和CT:肺少血表现为局部或者广泛肺血管减小减少,提示肺血流低于正常。(参考马赛克征和肺血重新分布)

四十五、机化性肺炎
病理:机化性肺炎的组织病理学特征是松散的结缔组织位于气腔和远端气道内。间质的炎症或者纤维化很轻,或者没有。原因不明性机化性肺炎是特发性间质性肺炎中比较特殊的一类。但是在多种情况下均可见机化性肺炎的组织病理学模式,包括肺感染,高反应性肺炎,胶原血管病。
平片和CT:在平片和CT上,机化性肺炎最主要的特征是含气腔隙的实变,在原因不明性间质性肺炎中,病变部位特征是胸膜下和基底段,有时候微软支气管。机化性肺炎的其它表现包括磨玻璃影,树芽征和结节影。

四十六、全腺泡性肺气肿
病理:全腺泡性肺气肿累及腺泡全部,累及次级肺小叶相对均一。主要累及下叶,该型肺气肿与抗胰蛋白酶缺乏有关。
CT:全腺泡性肺气肿表现为肺实质密度广泛性减低,病变肺的血管直径减小,严重的全腺泡性肺气肿可以与小叶中心性肺气肿并存并融合。乏特征性密度减低影与狭窄性闭塞性细支气管炎难以鉴别。与全小叶性肺气肿是同义词。

四十七、隔旁气肿
病理:隔旁气肿的特征是主要累及远端肺泡、肺泡管和肺泡囊。被胸膜表面和小叶间隔特征性分隔。
CT—本型气肿的特点是胸膜下和支气管血管旁的低密度区,被小叶间隔分隔,有时候伴发肺大疱。同义词是远端性腺泡气肿

四十八、parenchymal band 纤维索条影
平片和CT:纤维索条影是线样高密度影,常1-3mm厚,长125px,常延伸到脏层胸膜(脏层胸膜常常层厚,牵拉),代表胸膜和肺实质的纤维化,常伴随肺实质的牵拉。纤维索条影最常见于石棉曝露者。

四十九、肺实质密度增高影
平片和CT:肺实质密度增高影中,血管和气道壁的边缘可以模糊,也可以不模糊,实变代表密度增高影中,这些结构的边缘消失(空气支气管征除外)。磨玻璃征提示密度略微增高,其内结构的边缘清晰。肺实变和磨玻璃影使用更加广泛。
五十、-支气管血管旁间质
解剖:支气管血管旁间质是包绕支气管、肺血管、淋巴管的结缔组织鞘,从肺门延伸到肺周边部。
五十一、小叶周围性分布
解剖:小叶周围区域包括次级肺小叶周围的分界性结构。
CT:本征象的特征是病变沿肺小叶周边的分界性结构分布(例如小叶剑河、脏层胸膜和血管。本术语最常应用于病变主要位于次级肺小叶内层表面的情况(例如小叶周围性机化性肺炎)。本征象可以类似小叶间隔的不典型增厚

五十二、淋巴周围性分布
解剖:本征象的特征是病变在肺内沿着或者邻近淋巴管分布。淋巴组织位于支气管血管束、小叶间隔、肺部大静脉和胸膜。肺泡内无淋巴组织。
CT.—沿肺内淋巴系统路径发生的病变,即肺门病变、支气管血管束周围病变、小叶中心间质病变,小叶间隔病变、胸膜下病变,均为淋巴周围性分布。典型情况见于结节病(结节病)和癌性淋巴管炎。

五十三、胸膜斑
病理:胸膜斑是纤维透明性,相对无细胞的病变,主要来自胸膜的壁层,尤其是在膈上和肋骨下。胸膜斑几乎全部来自于长时间的石棉曝露史(至少15年)。
平片和CT:胸膜斑是边界清楚局部胸膜增厚,表现为局部的胸膜均匀或者结节状突起,常伴随钙化。(图)胸膜斑厚度不一,可以小于25px到125px直径。CT较平片容易发现病变。有时候胸膜斑可以类似肺内结节。

五十四、肺膨出
病理:肺膨出是肺内薄壁充气空腔。常由急性肺炎、外伤、吸入液态碳氢化合物,常常是一过性的。据认为机制是实质坏死、单向活塞形成导致的气道梗阻。
平片和CT:表现为肺内近圆形薄壁含气腔隙。

五十五、纵隔气肿
病理:纵隔气肿是指气体存在于食管和气管支气管树之外的纵隔组织内,可以是肺泡的自发破裂导致气体沿着气管血管间质进入纵隔所致。纵隔气肿与哮喘、重度咳嗽,或者机械通气有着明显联系。
平片和CT:纵隔气肿在胸片上显示为带状的透亮影,大多数垂直走向,见图。部分低信号条带影可以勾勒出血管和支气管的边界(参加心包气肿)

五十六、气胸和张力性气胸
病理:气胸指胸膜腔内出现气体。包括自发性、外伤性、诊断性和张力性气胸。张力性气胸是指胸膜腔内气体积聚,具有一定的压力。正常情况下,以此肺会完全压缩塌陷,而在顺应性减低的肺,可以保持膨胀不全。
平片和CT:在胸片上,可以看到脏层胸膜边,图55,除非气胸量很少,或者胸膜边缘与x线不呈切线位。张力性气胸可以出现明显的纵隔移位和/或一侧膈压低。一些非张力性气胸也可以出现纵隔移位,这是由于病变侧胸膜腔内压力达到大气压,而健侧胸膜腔压力为负造成的。
五十七、肺炎
病理:肺炎是肺实质和/或间质的炎症(例如感染,细菌性肺炎)。感染性肺炎的特征是导致实变的渗出性病变。本术语也用来指一系列肺实质的非感染性综合症,特征是不同程度的炎症和纤维化(例如非特异性间质性肺炎)
五十八、-心包气肿
病理:心包气肿是指心包腔内出现气体。通常是医源性的,手术性的,常见于成人。
平片和CT:心包气肿可以与纵隔气肿相互鉴别,因为气体导致的透亮影不会超出心包腔的范围。

五十九、进展性大范围肺纤维化
病理:本病源自粉尘的慢性积聚和病人曝露于无机粉尘后的的胶原增生(主要见于煤炭工人)
平片和CT:呈肿块样病变,常为双侧性,发生于上叶(图56)。结节状的背景密度异常提示尘肺,伴或者不伴大范围纤维化邻近的气肿性破坏。与进展性大范围纤维化相似的病变,也可以见于结节病和滑石病。

六十、假空洞
CT—假空洞表现为肺结节、肿块或者实变影内的圆形或者卵圆形低密度,反映的是相对正常的肺实质,或者扩张的支气管,或者局部肺气肿,而非空洞。假空洞的直径通常小于25px,可以见于腺癌(图)、细支气管肺泡癌和良性病变,例如感染性肺炎。

六十一、假胸膜斑
CT:假胸膜斑是与脏层胸膜相连续的肺内高密度,是小结节相互融合形成的。其外形类似与胸膜斑表现,本征象最常见于结节病,(图),硅肺和煤炭工人的尘肺。

六十二、肺血重新分布
病理:肺血重新分布是指由于肺血管床的肺血管阻力增加,引起肺血正常分布模式的改变。
平片和CT:肺血重新分布的提示征象是:一个或者多个区域的肺血管直径变小,或者数量减少,肺的其它部分肺血管直径或者数目相应的增加。二尖瓣病变病人上叶肺血重新分布是原始型(archetypal example)肺血重新分布的范例。

六十三、呼吸性细支气管炎-间质性肺病respiratorybronchiolitis–interstitial lung disease, or RB-ILD
病理:呼吸性细支气管炎-间质性肺病是一类与吸烟有关的病变,特征是呼吸性细支气管或者细支气管周围肺泡的炎症,主要是巨噬细胞浸润,有时候具有非特异性或者脱屑性间质性肺炎的特征
CT—呼吸性细支气管炎-间质性肺病的特征是广泛的小叶中心性小结节和片状的磨玻璃影,代表巨噬细胞成分为主的肺泡炎(图60),伴或者不伴细纤维化。常伴随支气管壁的增厚和小叶中心性肺气肿。空气滞留区域代表细支气管部分病变。

六十四、网状影
平片和CT.—在胸片上,网状影是大量细线状影的聚集,简言之,就是形成网状外观,(图)本征象一般代表间质性肺疾病。薄层CT显示网状影的成份更加清晰,可以是小叶间隔、小叶内线的增厚,或者是蜂窝征的囊壁。注意网状影和蜂窝征不是同义词。
六十五、网状结节影
平片和CT:是网状影和结节影重叠在一起。本征象常是大量线状影相互交叉时形成的小结节影。结节的大小和数量取决于线状影的大小和数量。在CT图像上,本征象表现为网状影和结节影同时出现。小结节可以位于网状影的中央(例如小叶中心性小结节),或者线样密度影上的结节(间隔结节)。

六十六、反晕征
CT.—反晕征是局限性圆形的磨玻璃影,周围绕以相对完整的环状实变影,图。本征象罕见,最先报道于不明原因性机化性肺炎,也可见与副球孢子菌病。

六十七、右侧气管旁带
解剖和平片:右侧气管旁带是垂直的线样软组织密度,宽度小于4mm,与右侧气管壁及相延续的纵隔组织和邻近胸膜相对应。在正位胸片上,此密度带高3-100px,大致从锁骨内侧端水平延续到右侧气管支气管角。可见与94%的成人,纵隔脂肪丰富的病例可以增宽或者阙如。右侧支气管旁带影增宽、变形或者消失最常见原因是气管旁淋巴结增大。

六十八、圆形肺不张
病理:圆形肺不张是与纤维性胸膜反折和小叶间隔增厚纤维化有关的圆形的肺组织塌陷。大多数情况下,是石棉所致渗出性胸腔积液继发胸膜瘢痕形成所致,也可以发生于其它原因所致的胸膜纤维化。
平片和CT:在胸片上,圆形肺不张表现为突出于胸膜表面的肿块影,.通常位于下叶的后部。血管扭曲呈弧形移位,并在肿块表面和内部聚拢(彗星尾征)。肺叶萎缩的程度取决于部长的肺容积。本征象常合并其它肺纤维化的征象(例如肋隔角变钝)。CT在显示圆形肺不张的特征方面更加敏感(图)。圆形肺不张的另一个特征是呈均匀强化。

六十九、边缘征象silhouette sign
平片:边缘征象是指解剖结构的软组织界面不清,由于邻近的肺组织实变或者/和不张、肿块、或者邻近胸腔积液造成(图)。边缘征象是由于邻近结构具有相近密度造成,本征象实际说的是边缘不清,并不一定指代疾病(例如无法解释的心脏有缘消失可以是与漏斗胸有关,有时候也见于正常人。

七十、胸膜下曲线影
CT—本征象是薄的曲线样密度,厚度1-3mm,离胸膜不到25px,与胸膜壁平行,(图)。如果见于卧位检查病人肺的后下部,则可以是不张的正常肺,当病人俯位行CT检查时,可以消失。也可以见于肺水肿病人,或者肺纤维化(可见其它征象)。虽然石棉肺有描述,但是不是石棉肺的特异性征象。

七十一、牵拉性支气管扩张或者细支气管扩张
CT:牵拉性支气管扩张和细支气管扩张是由于周围肺纤维化牵拉导致的支气管和细支气管的不规则扩张。扩张的气道可以如图所示,可以是囊状(支气管)或者是小囊状(细支气管)。多发囊样气道变形与单纯性纤维化所致蜂窝征难以鉴别。

七十二、树芽征
CT—树芽征代表小叶中心性分支结构呈发芽的树枝状。本征象代表一类细支气管内及其周围的病变,包括黏液嵌塞、炎症和/或纤维化(图)。与肺的周边部更加明显,常伴发大气道的异常。尤其常见于弥漫性全细支气管炎症,分枝杆菌的气道内播散和囊状纤维化。

七十三、一般间质性肺炎
病理:一般性间质性肺炎是肺纤维化的组织病理学特征,具有时间和空间上的不均一性,肺纤维化和蜂窝征散布于正常的肺之间。本病的关键征象包括成纤维病灶、肺结构的纤维性破坏和蜂窝征。纤维化先发生与肺的周边。一般间质性纤维化可见特发性间质性纤维化,但是也可发生于其它情况,例如高反应性肺炎。
平片和CT:肺底和胸膜下的蜂窝征具有诊断特异性,但是部分活检证实的一般间质性纤维化病例也可没有该特征性病变。

